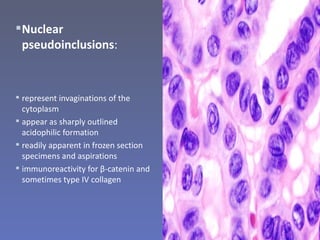
 Nuclear
  pseudoinclusions:



 represent invaginations of the
  cytoplasm
 appear as sharply outlined
  acidophilic formation
 readily apparent in frozen section
  specimens and aspirations
 immunoreactivity for β-catenin and
  sometimes type IV collagen

This document discusses various types of thyroid tumors. It first covers thyroid carcinomas including papillary carcinoma, follicular carcinoma, and other rare variants. Papillary carcinoma is the most common type and has characteristic nuclear features. Follicular carcinoma is diagnosed based on invasion of blood vessels or capsules. The document also discusses thyroid adenomas and other rare thyroid tumors. It provides detailed information on the histopathology, variants, molecular features, and prognosis of papillary and follicular carcinomas.